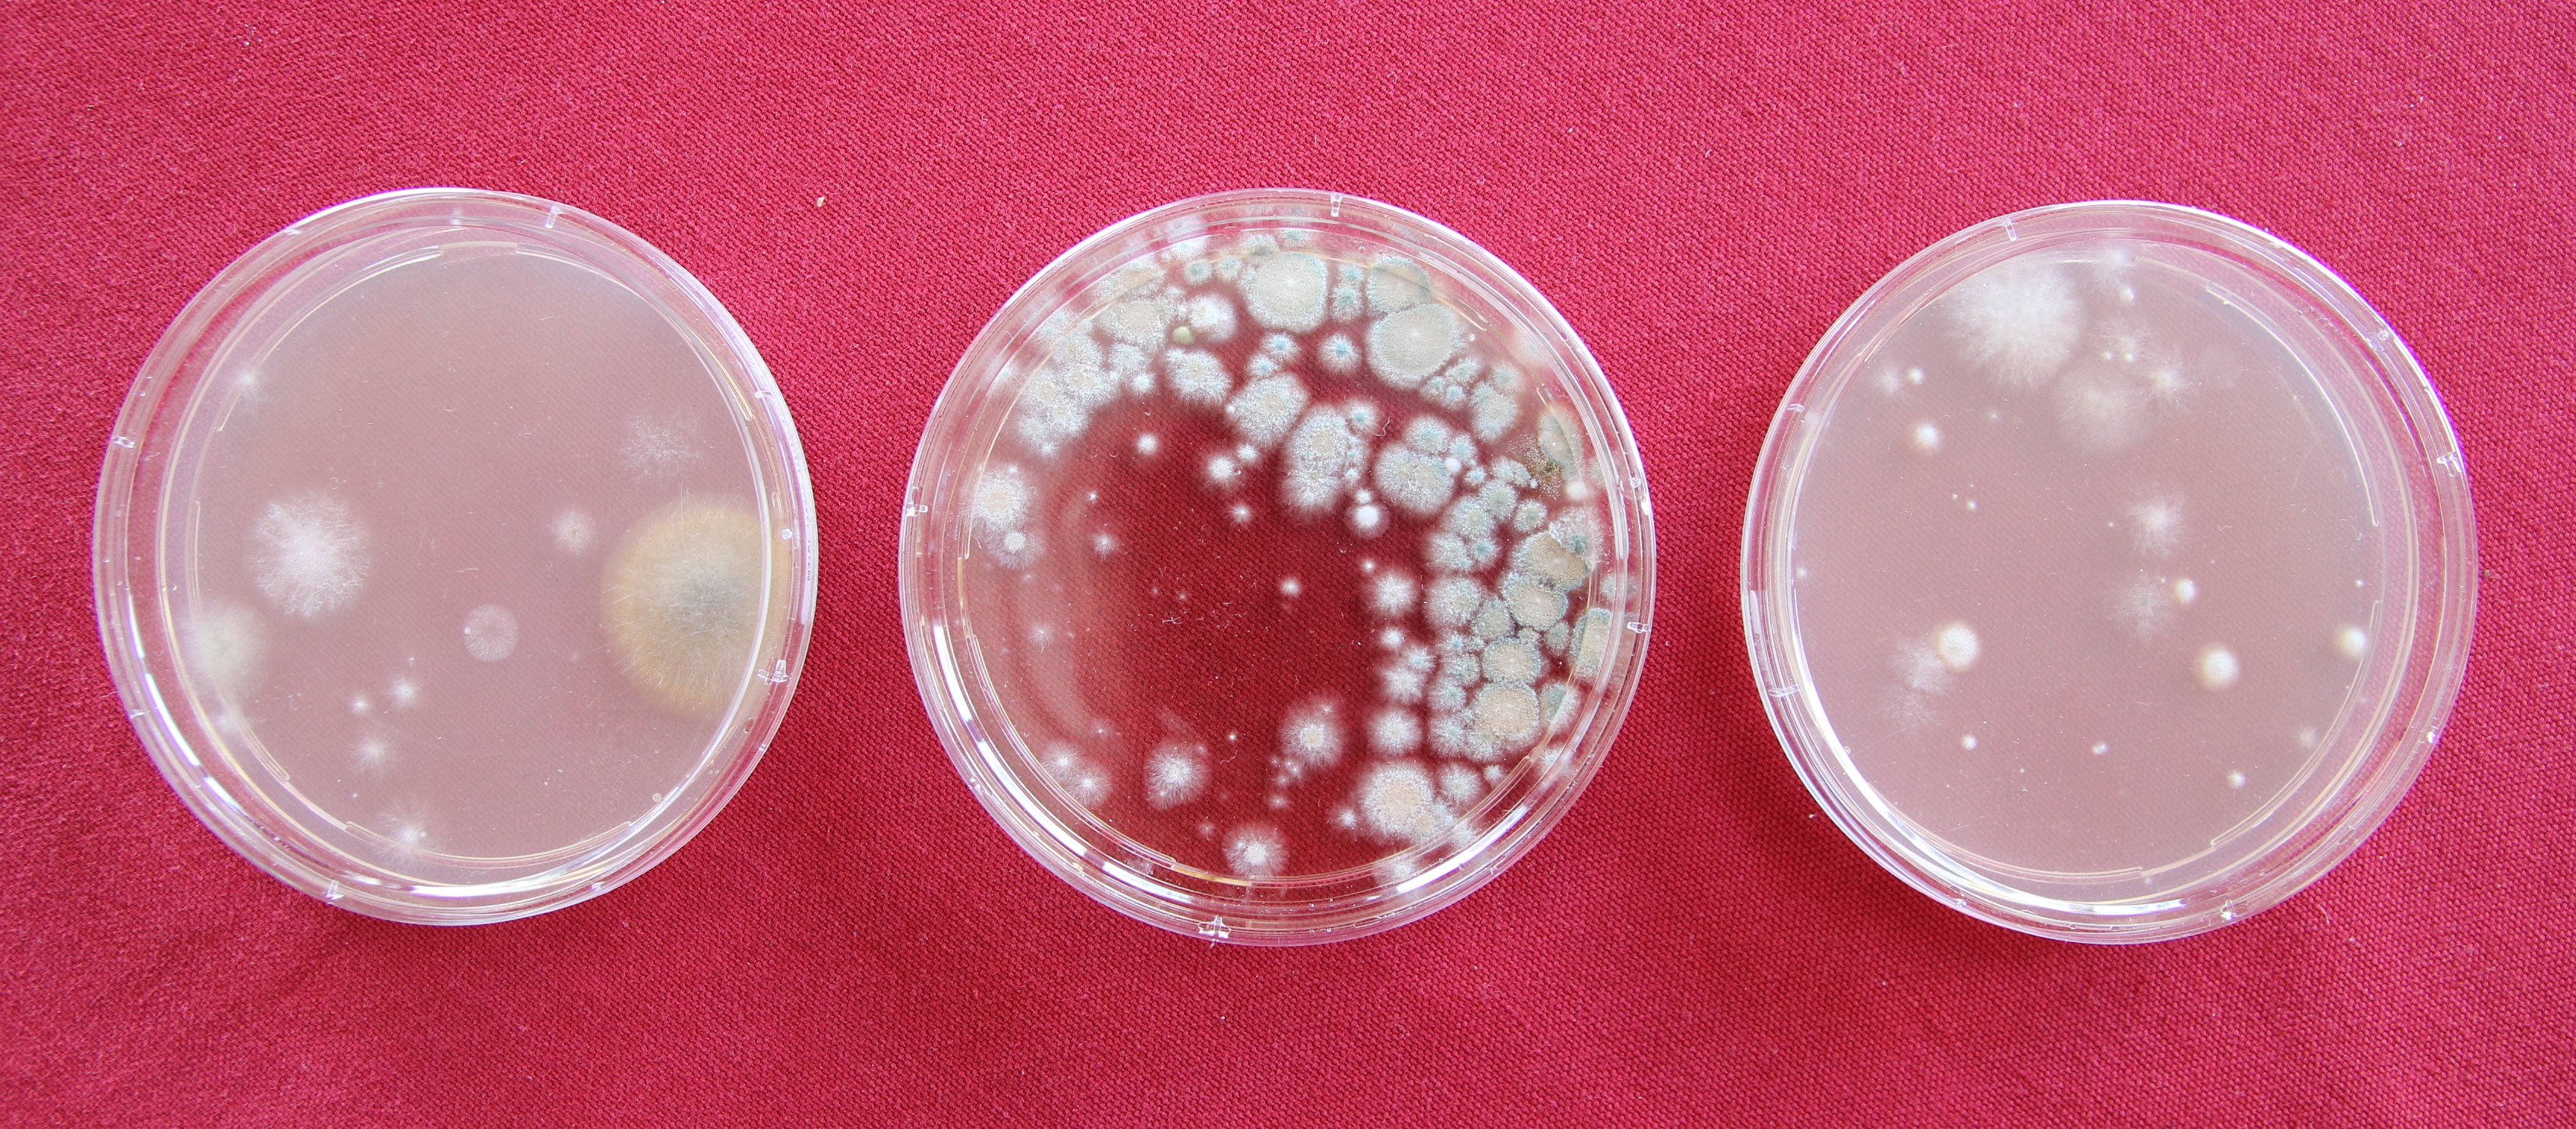

Schimmelpilze im Innenraum

Bei Feuchtigkeitsschäden am Gebäude wachsen bereits nach kurzer Zeit verschiedene Schimmelpilzarten, deren Sporen sich in der Raumluft ausbreiten und zu gesundheitlichen Beschwerden führen können. Wirksame Maßnahmen, um Schimmelpilzwachstum zu vermeiden, setzen die genaue Kenntnis der Schimmelpilze und ihrer Umweltansprüche voraus.
Die verschiedenen Schimmelpilzarten weisen unterschiedliche Proteinstrukturen auf und geben unterschiedliche Stoffwechselprodukte und Giftstoffe (Mykotoxine) ab. Körperfremde Proteinstrukturen sind häufig Auslöser von allergischen Reaktionen. Die krankmachende Bedeutung und Wirkung vieler Mykotoxine als luftgetragene Schadstoffe im Innenraumbereich sind noch weitgehend ungeklärt.
In schimmelpilzbelasteten Räumen klagen die Nutzer häufig über chronische, unspezifische Befindlichkeitsstörungen wie Reizungen der Augen, der Schleimhäute in Nase und Hals, ständig wiederkehrende "Erkältungen" (die nicht abzuheilen scheinen), Atemnot, Hautprobleme, Kopfschmerzen, Übelkeit, Schlafstörungen, untypisch schnelle Ermüdung, Reizbarkeit, allergische Reaktionen...
Oftmals entwickeln sich Schimmelpilze im Verborgenen. Ein modriger, muffiger Geruch oder erste dunkle Flecken an Wänden, Decken oder Mobiliar weisen auf das bestehende Problem hin. Vor der Durchführung von mikrobiologischen Analysen sollte zunächst eine Ortsbegehung stattfinden, um die möglichen Ursachen eines Schimmelpilzbefalls zu klären. Über eine Analyse der Raumluft, des Hausstaubs und/oder von befallenen Materialien kann das genaue Ausmaß des Schadens und das gesundheitliche Risiko eingeschätzt werden.

Bei größeren, sichtbaren Schimmelpilzschäden (> 20-50 cm2) z.B. hinter Schränken, Bildern, in Wandnischen oder an Fußleisten müssen keine aufwendigen Raumluftmessungen sein. Hier ist es wichtig, die Ursache des Schadens zu klären und eine fachgerechte Schimmelpilzsanierung durchzuführen. Eine solche Untersuchung setzt hohen Sachverstand voraus und sollte deshalb nur von Fachleuten durchgeführt werden. Es ist jeweils der konkrete Einzelfall unter Hinzuziehung aller vorhandenen Informationen zu beurteilen.